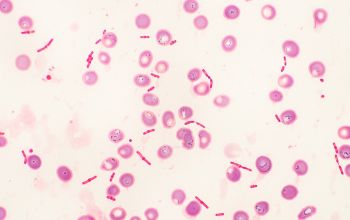
Escherichia coli Gram stain
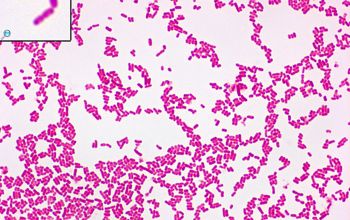
Escherichia coli Gram stain
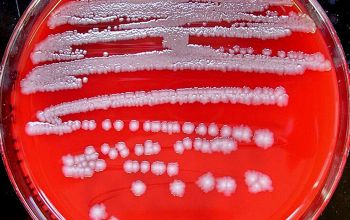
Escherichia coli Blood Agar 24h culture
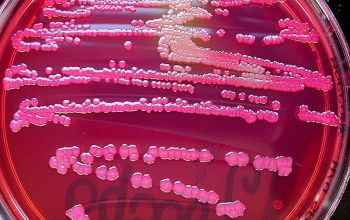
Escherichia coli Mac Conkey Agar without salt 24h culture
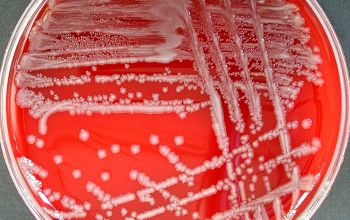
Escherichia coli Blood Agar 24h culture incubated with O2
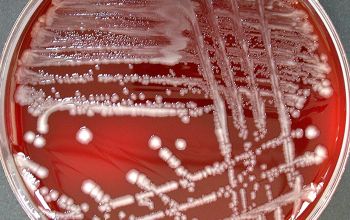
Escherichia coli Blood Agar 48h culture incubated with O2
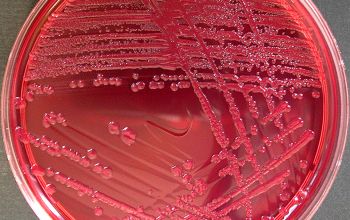
Escherichia coli Mac Conkey Agar without salt 24h culture incubated with O2
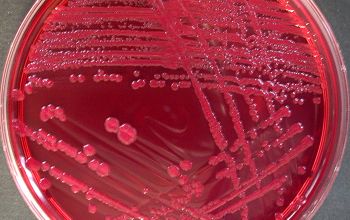
Escherichia coli Mac Conkey Agar without salt 48h culture incubated with O2
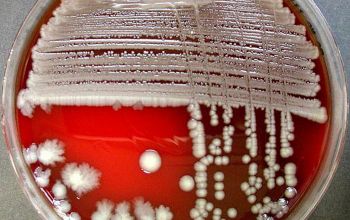
Escherichia coli Blood Agar 48h culture incubated with O2

Escherichia coli
-
General information
Taxonomy
Family: Enterobacteriaceae, genus: Escherichia coli
E. albertii, E. fergusonii, E. hermannii, E. vulneris
Natural habitats
Widely distributed in nature, water, soil, foods and clinical samples.
The genus Escherichia will occupy the last part of the small intestine and the large intestine in humans and warm-blooded animals. In more than 99% of the isolates, it is a Escherichia coli.
E. coli is a good indicator of the water it is clean. (fecal contamination)
Clinical significance
They are generally located in the intestinal lumen (colon), but some strains can cause a variety of infections, enteritis, septicemia, peritonitis, urinary infections, meningitis (neonatal) etc, in humans and animals.
-
Diseases
-
Gram stain
Gram negative rods,
1-3 x 0.5 µm, though their size can be impacted by temperature, growth state, and exposure to antibiotics.
They occur singly or in pairs
-
Culture characteristics
-
Facultative anaerobic
BA: colonies appear round, smooth (S-type), low convex, moist and gray with a shiny surface, entire edge. R-type or mucoid forms may occur.
Some strains may demonstrate a narrow zone of β-hemolysis.
McConkey:
lactose fermenter: colonies are flat, dry and pink
non lactose fermenter: colonies are pale (5%)
BBAØ: growth
-
-
Characteristics
-
References
James Versalovic et al.(2011) Manual of Clinical Microbiology 10th Edition
Karen C. Carrol et al (2019) Manual of Clinical Microbiology, 12th Edition